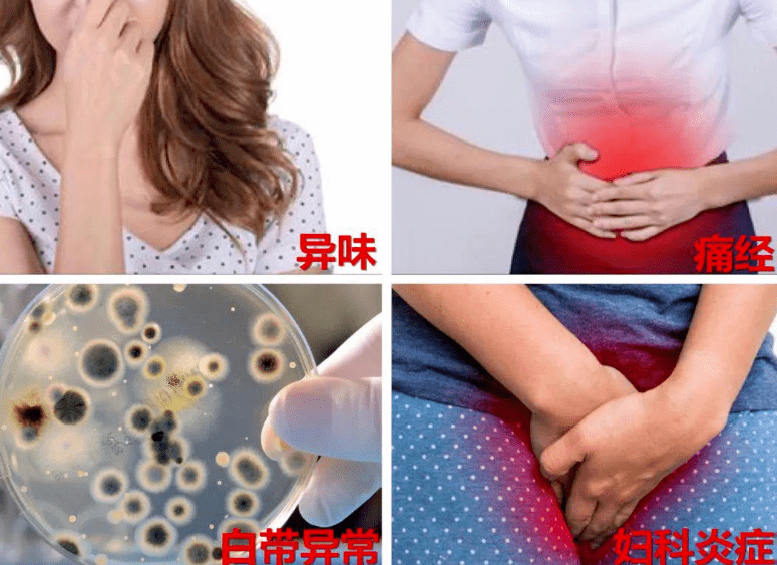
02妇科炎症包括盆腔炎,阴道炎,外阴炎,宫颈

外阴炎感染症状图片

外阴阴道假丝酵母菌病和滴虫性阴道炎等,也有部分为需氧菌感染
图片尺寸600x393
女童尿频尿痛竟是外阴炎惹的祸
图片尺寸610x516
外阴炎外阴炎比较容易在阴道炎患者身上同时出现,患上外阴炎的患者
图片尺寸900x600
的刺激可引起外阴瘙痒及灼热感,也可出现经间期出血,性交后出血等症状
图片尺寸500x574
私处长了小疙瘩警惕hpv感染尖锐湿疣
图片尺寸660x330
"十个女性九个炎",妇科炎症有哪些!_症状_外阴_阴道
图片尺寸1005x669
宝宝得了外阴炎只因妈妈做错了这件事
图片尺寸883x719
女生患有外阴炎有什么症状?会不会传染?
图片尺寸500x315
妇科炎症用药霉菌性滴虫阴道炎细菌念珠菌外阴阴道病混合感染 6粒装*1
图片尺寸790x1238
阴道炎怎么引起的
图片尺寸400x235
大部分阴道炎都是微生物感染的结果 门诊最多见的病原体是真菌(霉菌
图片尺寸534x395
宝宝得了外阴炎?只因妈妈做错了这件事!
图片尺寸640x256
女性避免感染外阴炎需要做到以下几点:01.
图片尺寸504x317
当孕期遇上阴道炎!这样处理,安全不伤胎_外阴
图片尺寸1240x872
02妇科炎症包括盆腔炎,阴道炎,外阴炎,宫颈
图片尺寸777x565
抗干扰素凝胶女性产后私护宫颈糜烂阴道炎瘙痒异味1盒体验装阻断感染
图片尺寸790x600
霉菌性_阴炎_外阴
图片尺寸1080x636
阴道炎是女生的"噩梦"?这5种常见类型得及早发现_外阴_滴虫性_症状
图片尺寸640x363
男性在感染念珠菌后具有一定的隐匿性,一般情况下没有症状或症状较轻
图片尺寸543x426
指南对比为规范其诊治,中华医学会妇产科学分会感染性疾病协作组于
图片尺寸1080x525